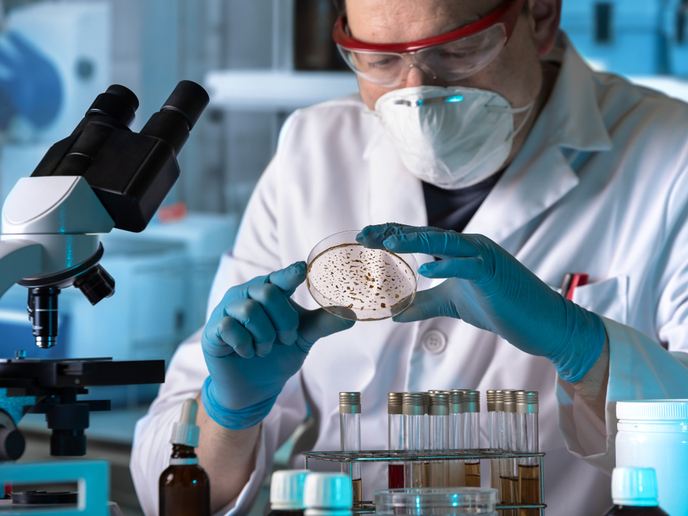

Remplacer les solvants dangereux par des solutions plus sûres et renouvelables
Les solvants sont une classe de produits chimiques qui peuvent dissoudre, mettre en suspension ou extraire d’autres substances sans en modifier les propriétés physiques. Selon le groupe European Solvents Industry Group(s’ouvre dans une nouvelle fenêtre), les fabricants de solvants produisent 5 millions de tonnes de solvants chaque année, contribuant à hauteur de 4 milliards EUR à l’économie européenne(s’ouvre dans une nouvelle fenêtre). Or, certains solvants issus de la pétrochimie sont hautement toxiques. Le projet ReSolve(s’ouvre dans une nouvelle fenêtre) a exploré des alternatives plus sûres et biosourcées pour remplacer deux solvants dangereux que les industries européennes utilisent abondamment: le toluène et la N-Méthyl-2-pyrrolidone (NMP). ReSolve a bénéficié d’un financement dans le cadre de l’entreprise commune Bio-industries, un partenariat public-privé entre l’UE et les bio-industries. Grâce à leur expertise dans le domaine des matières premières de la biomasse et des produits chimiques renouvelables, les chercheurs ont développé des solvants de substitution basés sur des hydrates de carbone non alimentaires. La sécurité des nouveaux solvants a été évaluée à l’aide de modèles in silico afin de prédire le comportement biologique et de tests biologiques in vitro destinés à évaluer le comportement chimique réel avant de passer au stade du développement. Des évaluations technico-économiques et de viabilité ont été réalisées afin d’optimiser la conception des processus pour la production industrielle et de comprendre leur impact réel sur la nature. «Bien que les coûts de fabrication des solvants nouvellement développés soient plus élevés que ceux des solvants conventionnels, ils sont jugés acceptables si l’on considère que ces solvants nécessitent des usines de production inédites», observe James Clark, professeur à l’Université de York (Royaume-Uni). «De plus, la production des solvants ReSolve ne rejette en général que deux tiers des substances nocives émises par les solvants pétrochimiques.»
Des solvants alternatifs prometteurs et biosourcés
Les chercheurs ont synthétisé le 2,2,5,5-tétraméthyloxolane (TMO), un solvant non polaire aux propriétés similaires à celles du toluène, pour l’utiliser dans la production de films adhésifs. «Ce solvant biosourcé a le potentiel de remplacer non seulement le toluène mais également d’autres solvants dangereux. Il affiche des performances similaires à celles du toluène dans les réactions chimiques. La solubilité de certaines substances s’est même améliorée dans certaines applications où le TMO a été testé», ajoute James Clark. «Le TMO peut grandement profiter aux processus d’extraction et à la biocatalyse, où la performance des processus est limitée par la solubilité des substances essentielles.» L’équipe du projet a également synthétisé une alternative plus sûre et biosourcée appelée dihydrolevoglucosenone(s’ouvre dans une nouvelle fenêtre) (Cyrene™) pour remplacer le NMP, un solvant pour lequel l’UE a imposé des conditions strictes d’utilisation tant pour la sécurité des employés que pour la durabilité environnementale. Le Cyrene™, qui est produit à partir du traitement de la sciure de bois usagée avec de l’acide, reproduit de manière efficace les propriétés du NMP sans pour autant nuire à la santé. Le partenaire du projet Circa Group(s’ouvre dans une nouvelle fenêtre) a entrepris la construction d’une usine en France qui produira 1 000 tonnes de Cyrene™ biosourcé par an. Outre le TMO et le Cyrene™, les chercheurs ont testé d’autres solvants prometteurs à base de glucides en vue de remplacer le NMP, le toluène et d’autres solvants dangereux. Leur méthodologie pourrait également être reproduite pour le développement de polymères durables, recyclables et biosourcés.
Vers une industrie chimique plus viable
Il ne suffit pas de remplacer les solvants dangereux par des substituts non biosourcés dans diverses applications de produits quotidiens pour dissiper les inquiétudes en matière de santé et rendre la fabrication de produits chimiques moins coûteuse et plus écologique. Le nombre limité d’alternatives non biosourcées et sûres devrait soulever des problèmes de toxicité similaires, et l’utilisation de nombreux produits chimiques traditionnels sera probablement limitée dans un avenir proche. ReSolve a réussi à synthétiser et à tester deux solvants biosourcés qui pourraient remplacer le toluène et le NMP, à évaluer les coûts de production et à identifier les marchés cibles. Des recherches supplémentaires doivent encore être menées pour identifier et évaluer d’autres solvants, car une approche unique ne pourrait pas répondre aux exigences de différentes applications.